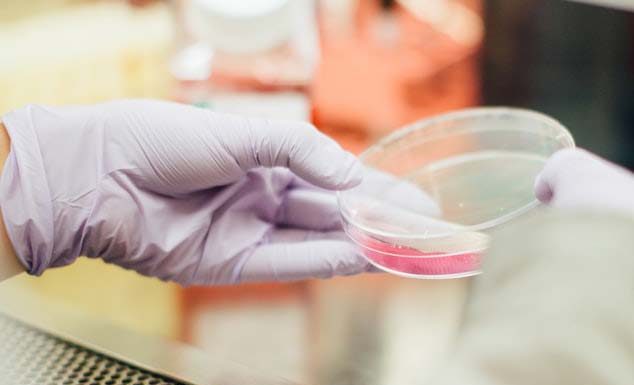
호주 지역감염 무행진에 백신 접종 22일 실시

메리 하워드(75)는 25일 오후 1시가 조금 넘은 시각 시드니에서 북쪽으로 75km 떨어진 위즈먼스 페리에 있는 호크스베리강 옆을 운전하다가 싱글턴로드에서 추락했다. 그녀가 타고 있던 하얀 도요타 코롤라 세단은 도로를 벗어나 덤불을 뚫고 호크스베리강으로 가라 앉았다.
하워드씨는 두 다리에 큰 부상을 입고,...
2월 21일 일요일 새벽 1시 30분경, 25세의 한 남성이 뱅스타운 데일 퍼레이드에 주차 후 앉아 있던 와중, 칼로 무장한4명의 남성들이 접근했다.
이들은 운전자의 지갑과 돈을 요구한 뒤, 차에서 끌고 나와 폭행하고 다리 등을 칼로 찌른 것으로 알려졌다고9News가 말했다. 뱅스타운 소속...
84세 노인 총리와 시드니에서 첫 접종
스콧 모리슨 총리가 호주 첫 노인 백신 접종자 84세의 제인 멜리시니 노인과 대화를 나누고 있다.
총리는 시드니 카슬힐 메디컬 센터에서 이 노인과 백신주사를 맞았다.
21일은 호주 코로나 확산을 막는 바이러스와의 전쟁 2라운드가 시작된 기념비적인 날이다. 이날...
38일째 지역 무 감염 행진 최고 기록
NSW주정부는 주 내 무 감염행진이 계속되자 26일부터 현행 여러 제재조치를 완화했다. 가정 방문자가 50명까지 허용됐다. 결혼식 파티에서 30명까지 춤을 출 수 있고, 4스퀘어미터 거리두기와 마스크를 착용하면 교회 성가대 합창이 가능하다.
영화관은 수용인원의 1백퍼센트까지 허용된다.
실내...
옥스포드 거리의 과속, 신호위반 카메라가 하루에 3백건의 위반 차량을 적발했다.
시드니 시티 달링허스트 옥스포드 거리의 2중 과속, 신호위반 카메라가 지난 9월 중 하루에3백건의 위반차량을 적발했다. 거둬들인 벌금만 1백50만불이다. 작년 9월이후 이 곳 2대의 과속, 신호위반 카메라는 과속 차량 36,667대에6백만불의...
웨스트미드, 리버풀, RPA백신 거점병원 지정
웨스트미드 병원 응급실의 단테 카네트 간호사(사진)가 이 병원에서 첫 백신주사를 맞았다. 4명의 자녀를 둔 올해 49세의 카네트 간호사는 코로나 바이러스 방역과 치료의 최전선 병원에서 근무하고 있다. 이에 앞서 백신주사 하브의 하나인 RPA병원의 보건요원이 백신주사를 맞았다.
주정부는...
호주인들 중 몇몇 소비자들이 그들이 지불한 상품을 받지 못했고 재정적인 보상을 받을 수 없게 되었기때문에 온라인 약국을 이용하지 말라는 경고를 받았다.
NSW공정거래위원회 로즈 웹은 소비자들은 discountepharmacy.com.au을 취급하지 말라는 내용의 공개 경고를 냈다. 웹은 이 같은 경고는 소비자들로부터 지불된 상품을 받지...
시드니 남서부의 한 주택 파티 밖에서 한 남성이 경찰관의 얼굴을 주먹으로 때리고 의식을 잃게 한 혐의로 월요일 법정에 출두할 예정 이라고 9NEWS가 보도했다. 이 파티의 주최자인 샤론 에테우아티는 일요일 새벽 1시가 조금 넘은 시각 랜스베일 헌팅데일 애비뉴의 집 밖에서...
클럽 포커 머신에 불똥 ‘베팅 카드’ 구상
시드니 바랑가루 크라운 카지노에 검은 그림자가 드리워졌다.
크라운 카지노 면허소지 발급이 부적합하다는 판정에 개장 앞날이 불투명하다.
범죄 조직단의 검은 돈 세탁으로 제임스 패커의 야심작 시드니 바랑가루 크라운 카지노의 장래에 검은 그림자다 드리워졌다. 2019년 카지노...
“호주인 안전보호 희망의 서광”
전국 지역감염 무행진에 백신 접종 22일 실시
15일 시드니에 화이자 백신이 도착했다. 22일부터 첫 접종이 실시된다.
화이자 백신이 15일 호주 땅에 상륙했다. 14만2천명분이 이날 오후 시드니에 도착해 오는 22일 첫 신종 코로나바이러스 백신접종에 들어간다. 안전성 여부로 논란을...